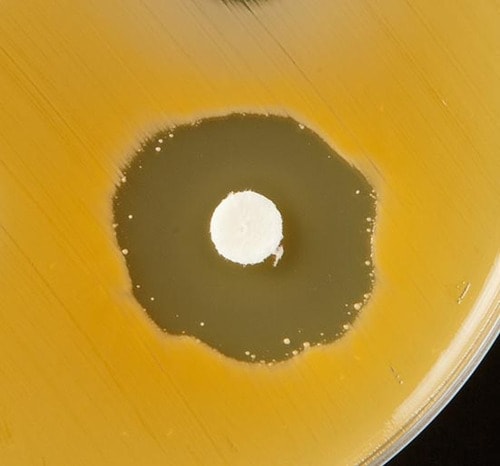
【テスト方法】食中毒菌とスポンジ 洗剤を垂らして除菌力をチェック イメージ
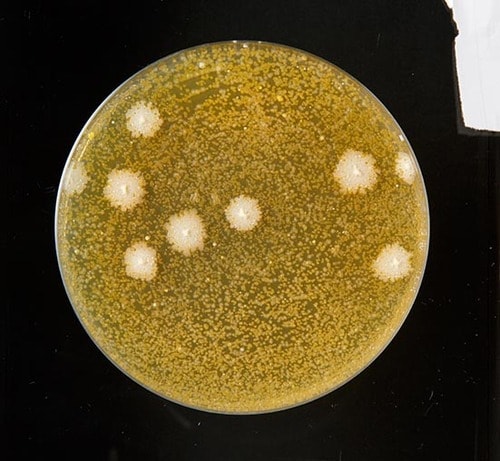
【テスト方法】食中毒菌とスポンジ 洗剤を垂らして除菌力をチェック イメージ3
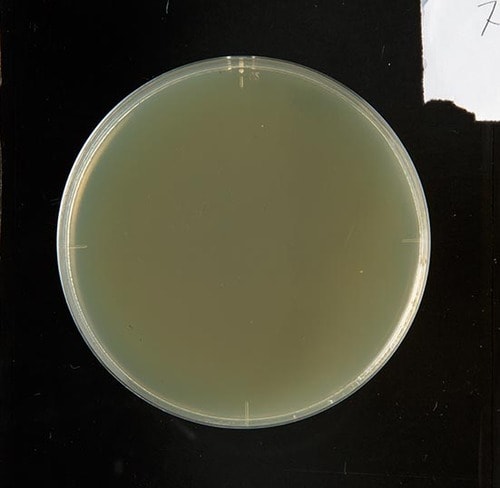
【テスト方法】食中毒菌とスポンジ 洗剤を垂らして除菌力をチェック イメージ4
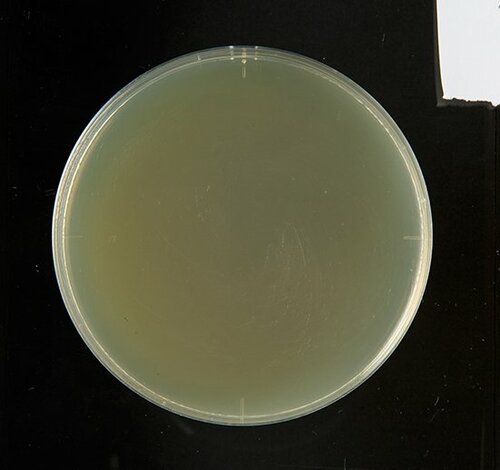
【A評価】あらゆる菌を除去! シャボン玉台所用せっけん イメージ
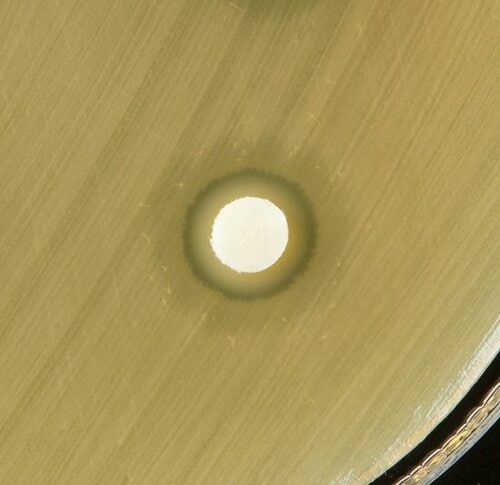
【A評価】あらゆる菌を除去! シャボン玉台所用せっけん イメージ2
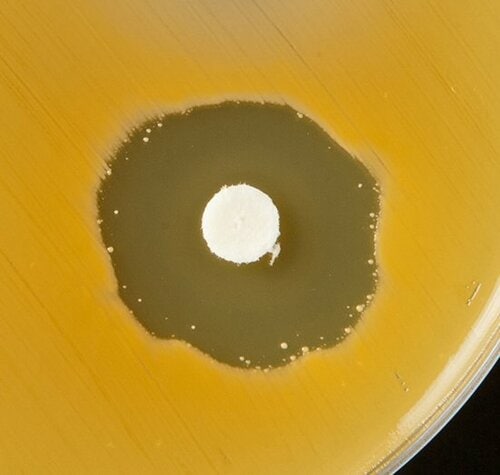
【A評価】あらゆる菌を除去! シャボン玉台所用せっけん イメージ3
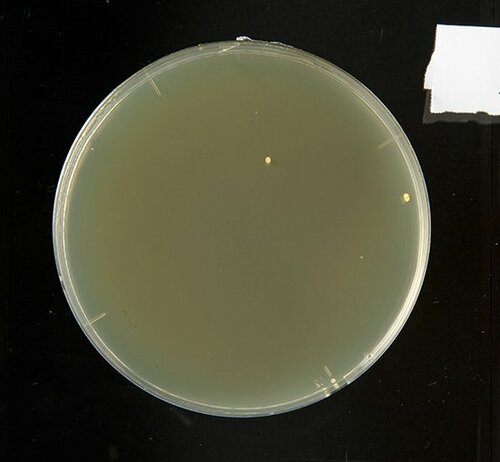
【A評価】十分な除菌力を発揮 CHARMY Magica イメージ
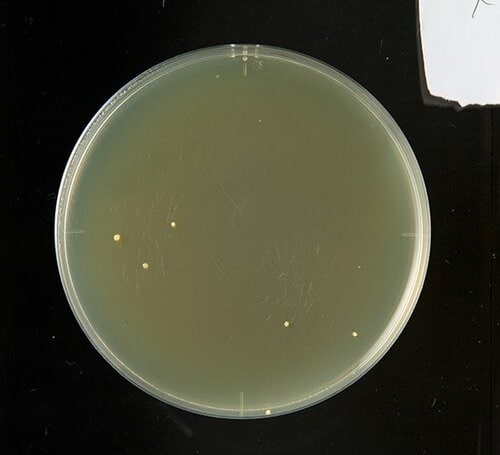
【A評価】まんべんなく効果アリ ! ファミリーフレッシュ イメージ
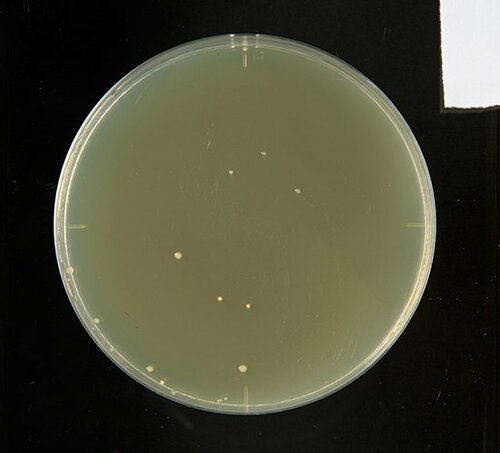
【A評価】マイルドでも除菌力は しっかり! チャーミーマイルド イメージ
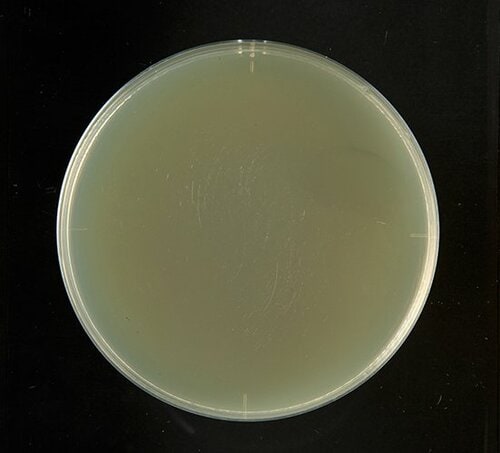
【A評価】スポンジへの効果は絶大 除菌ジョイコンパクト イメージ
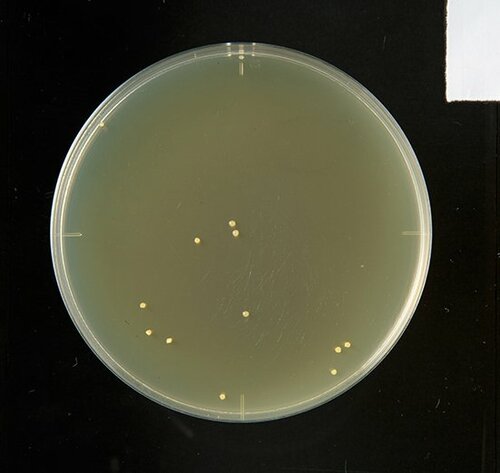
【B評価】大腸菌は減らす 残念な結果のキュキュット イメージ
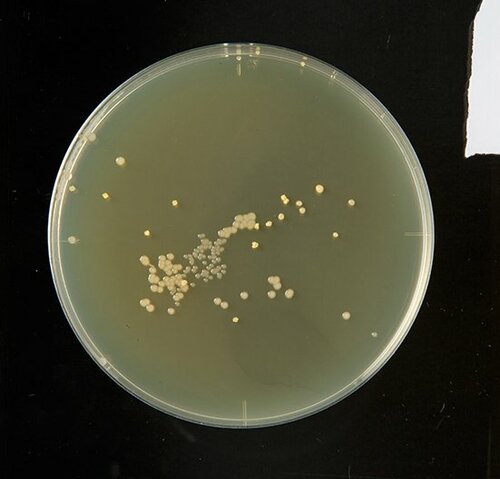
C評価: 【C評価】大腸菌以外効果ナシ 落ちる泡のチカラ手肌プレミアム イメージ

除菌をうたう14製品から 最強の食器用洗剤を決定!
毎年恒例となっている、テストする女性誌『LDK』による食器用洗剤ベストランキング。
今年のテストのポイントは、ズバリ「除菌力」。LDK2017年1月号で行った「洗浄力」「泡立ち・泡もち」「手肌へのやさしさ」3つのテストに加え、専門機関の協力のもと「除菌力」テストを導入し、汚れも菌も落として、本当に食器がキレイになる洗剤を探しました。
今回は、その「除菌力」テストのランキングをご紹介していきたいと思います。
※企画の概要はこちら▼
キッチンに潜むあらゆる菌を 減らす洗剤を検証しました
食べ物を扱うキッチン、キレイにしているつもりでも、じつは菌がいっぱい。なかでも食器洗い用スポンジの一般生菌の数は、何と1億個以上と、トイレブラシに匹敵するという驚愕の数字なんです。
ベストとなった洗剤は、そんなキッチンに潜むあらゆる菌の繁殖を防ぐダントツの除菌力を発揮。一方ワースト洗剤は、除菌をうたっていながら、ほとんどの菌に効果がないという結果に……。
気になる結果は、テスト方法につづき発表していきます。
【テスト方法】食中毒菌とスポンジ 洗剤を垂らして除菌力をチェック
専門機関の協力のもと、「大腸菌」と「黄色ブドウ球菌」などを培養し、そこに洗剤に浸した紙を置き、円の大きさで除菌力を見ました。
除菌力が高い洗剤だと、洗剤まわりに菌がおらず食中毒の予防になります。

除菌力が低いと、原因菌を除去できていません。
実際に使ったスポンジも、培地にこすり洗剤を垂らして繁殖を確認しました。
洗剤を垂らす前のスポンジには菌がたくさん……。
除菌できる洗剤だとこんなにキレイになりました!
それでは、とにかく菌を減らすことができる「除菌力」ベストとなった洗剤からご覧ください。
【A評価】あらゆる菌を除去! シャボン玉台所用せっけん
除菌力ベストとなったのは「シャボン玉石けん」。脂肪酸カリウムなどの純石けん分による、弱アルカリの液性が菌を除去します。この除菌力なら、食中毒の予防も期待できます。

シャボン玉石けん
シャボン玉 台所用せっけん
実勢価格:294円/300ml
液性:弱アルカリ性
[スポンジについた菌の除菌力]
「大腸菌」と「黄色ブドウ球菌」以外にも食中毒の原因となる雑菌はいますが、スポンジの菌をここまで除菌できれば安心です。
[大腸菌の除菌力]
ほかの洗剤と比べて、洗剤のまわりはしっかり除菌できました。
[黄色ブドウ球菌の除菌力]
バツグンの除菌力で、黄色ブドウ球菌は洗剤のまわり一帯に繁殖できませんでした!
とにかく除菌をしたい! というときは、シャボン玉石けんがオススメなことは間違いありません! 次からは、多くの細菌に対して効果を発揮するA評価の洗剤、8製品をご紹介します。
【A評価】十分な除菌力を発揮 CHARMY Magica
いろいろな菌に十分な効果を発揮した「CHARMY Magica」。スポンジについた菌には特に効果が高かったんです。

ライオン
CHARMY Magica
スプラッシュオレンジの香り
実勢価格:138円/230ml
液性:中性
スポンジについた菌:◎
黄色ブドウ球菌:△
大腸菌:○
これだけ除菌できていれば十分!
【A評価】まんべんなく効果アリ ! ファミリーフレッシュ
油汚れにもそこそこ強かった「ファミリーフレッシュ」は、菌に対してもまんべんなく効果を発揮しました。

花王
ファミリーフレッシュコンパクト
実勢価格:127円/270ml
液性:中性
スポンジについた菌:○
黄色ブドウ球菌:○
大腸菌:○
いろいろな菌に対して、平均的に効果がありました。
【A評価】マイルドでも除菌力は しっかり! チャーミーマイルド
手肌をいたわるマイルドタイプの台所用洗剤「チャーミーマイルド」は、洗浄力テストではC評価といまいち奮いませんでしたが、除菌力はあります。

ライオン
チャーミーマイルド
実勢価格:162円/260ml
液性:中性
※Amazonパントリーの価格です
ASIN: B01LX719A3
スポンジについた菌:○
黄色ブドウ球菌:○
大腸菌:○
マイルドですが、除菌力はしっかりあります。
【A評価】スポンジへの効果は絶大 除菌ジョイコンパクト
除菌に特化した「ジョイコンパクト」は、たくさんの菌が潜むスポンジへの効果が際立ちました。

P&G
除菌ジョイコンパクト
実勢価格:106円/190ml
液性:弱アルカリ性
スポンジについた菌:◎
黄色ブドウ球菌:△
大腸菌:△
スポンジの除菌力の高さは、嬉しいです。
【A評価】しっかり除菌 CHARMY Magica除菌+
CHARMYの除菌シリーズ。「除菌+」とうたっているのは、ダテじゃありませんでした。

ライオン
CHARMY Magica除菌+
実勢価格:160円/220ml
液性:中性
スポンジについた菌:◎
黄色ブドウ球菌:○
大腸菌:○
【A評価】スポンジ除菌に強い チャーミーVクイック
洗浄力テストでトップだった「チャーミーVクイック」は、スポンジ除菌もバッチリです。

ライオン
チャーミーVクイック
実勢価格:190円/260ml
液性:中性
スポンジについた菌:◎
黄色ブドウ球菌:○
大腸菌:○
【A評価】シリーズでは最高 キュキュットクリア除菌
今回、キュキュットシリーズは3製品エントリーしていますが、その中で除菌力が最高だったのが、「クリア除菌」でした。

花王
キュキュットクリア除菌
実勢価格:130円/240ml
液性:弱酸性
※Amazonパントリーの価格です
スポンジについた菌:○
黄色ブドウ球菌:○
大腸菌:○
【A評価】スポンジ除菌に強い! サンドラッグホワイトライター
洗浄力ではB評価だったドラッグストア・サンドラッグのオリジナル洗剤は、スポンジの菌をガッツリ除菌できました。
サンドラッグ
ホワイトライターライムの香り
実勢価格:321円/800ml
液性:中性
スポンジについた菌:◎
黄色ブドウ球菌:○
大腸菌:○
以上が、安心して除菌を任せられるA評価となった8製品でした。つづいてはB~C評価の製品6製品。B評価の洗剤は一部の菌を減らすことはできましたが、C評価の洗剤は、あまり除菌効果は高くありませんでした。
【B評価】大腸菌は減らす 残念な結果のキュキュット
「キュキュット」は、大腸菌を減らすことはできましたが、黄色ブドウ球菌やスポンジへの効果は薄かったです。

花王
キュキュット
実勢価格:216円/240ml
液性:中性
スポンジについた菌:△
黄色ブドウ球菌:△
大腸菌:○
スポンジの菌は少し残りました。
【B評価】食中毒菌は減らせた キュキュットハンドマイルド
手肌ケアをうたう「キュキュットハンドマイルド」は、スポンジの菌以外には効果がありました。

花王
キュキュット
ハンドマイルドカモミールの香り
実勢価格:154円/230ml
液性:中性
※Amazonパントリーの価格です
スポンジについた菌:×
黄色ブドウ球菌:○
大腸菌:○
【B評価】大腸菌を減らすなら PB界の代表セブンプレミアム
洗浄力テストでA評価という好成績だったセブンプレミアムは、大腸菌のみしっかり減らしてくれました。
セブンプレミアム
食器用洗剤オレンジの香り
実勢価格:108円/240ml
液性:中性
スポンジについた菌:△
黄色ブドウ球菌:△
大腸菌:○
C評価: 【C評価】大腸菌以外効果ナシ
落ちる泡のチカラ手肌プレミアム
「チャーミー」の手肌ケアタイプは、モコモコとした泡で汚れを落としてくれましたが、除菌力では、大腸菌以外は効果が薄いという結果に……。

ライオン
CHARMY
泡のチカラ手肌プレミアム
実勢価格:225円/240ml
液性:中性
スポンジについた菌:△
黄色ブドウ球菌:×
大腸菌:○
大腸菌は減らしましたが、スポンジは菌が残っています。
C評価: 【C評価】除菌はスポンジだけ
トップバリュの食器用洗剤
洗浄力ではC評価とのトップバリュ、除菌力でもC評価に……。除菌できたのはスポンジだけで、今のところいいトコがありません。
トップバリュ
食器用洗剤
JUICY ORANGE
実勢価格:105円/250ml
液性:弱アルカリ性
スポンジについた菌:◎
黄色ブドウ球菌:×
大腸菌:×
【除菌力結果】とにかく菌を 減らすならシャボン玉石けん!
食べ物を扱うキッチンを、キレイに保てるのは「シャボン玉石けん」に決まり! 2つの代表的な食中毒菌をはじめ、ほかの原因菌を含む可能性があるスポンジも除菌できた除菌力ベスト洗剤です。
ご協力いただいた専門家の方たち

(左)神奈川歯科大学 微生物感染学分野 佐々木 悠 先生
微生物感染学分野で講義等を行う博士(歯学)
(右)神奈川歯科大学 微生物感染学分野 稲葉啓太郎 先生
歯科大学にて微生物感染学分野で活躍する歯科医師

FCG総研
フジサンケイグループの研究機関。商品テストの実績に定評あり
次回は、「泡立ち・泡もち」テストの結果を発表です! お楽しみに。






